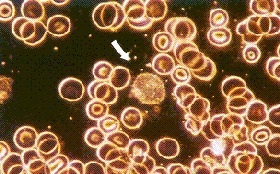
442) Simply astonishing. This indicates that microorganisms such as bacteria are indeed pleomorphic, and further implies that there is an elementary unit of life (i.e., Béchamp’s microzyma) from which pleomorphic microorganisms emanate.

416) “The day will come when all nations amidst which the Jews are dwelling will have to raise the question of their wholesale expulsion, a question which will be one of life or death, good health or chronic disease, peaceful existence or perpetual social fever.” – Franz Liszt
417) “Use the courts, use the judges, use the constitution of the country, use its medical societies and its laws to further our ends. Do not stint in your labor in this direction…”
418) “…And when you have succeeded you will discover that you can now effect your own legislation at will and you can, by careful organization, by constant campaigns about the terrors of society…”
419) “…by pretense as to your effectiveness, make the capitalist himself, by his own appropriation, finance a large portion of the quiet Communist conquest of that nation.” – Lavrentiy Pavlovich Beria
420) While vaccines were arguably the biggest contributor to the massive death toll in the 1918 pandemic, there were other prominent sources of mass fatalities that have been largely overlooked.
421) It’s critical to highlight these, as they demonstrate just how devastating a corrupt medical establishment can be when it is equipped with a lie as monstrous as the Jewish-inspired germ theory.
422) Aspirin was another major cause of death in the 1918 pandemic, as indicated by the articles below.
https://academic.oup.com/cid/article/49/9/1405/301441
https://www.lewrockwell.com/2009/10/bill-sardi/did-aspirin-contribute-to-flu-deaths/
https://www.winterwatch.net/2020/03/aspirin-contributed-to-mortalities-of-1918-1919-spanish-influenza-and-more/
https://academic.oup.com/cid/article/49/9/1405/301441
https://www.lewrockwell.com/2009/10/bill-sardi/did-aspirin-contribute-to-flu-deaths/
https://www.winterwatch.net/2020/03/aspirin-contributed-to-mortalities-of-1918-1919-spanish-influenza-and-more/
423) Radio waves were apparently another major contributor to the death toll.
“The 1918 Spanish flu pandemic was caused by the sudden influx of radio waves all over the planet. During World War II the invention of radar triggered a similar death toll.”
https://johnkaminski.org/index.php/john-kaminski-american-writer-and-critic-2/247-pandemic-panic-a-poisoned-psyop
“The 1918 Spanish flu pandemic was caused by the sudden influx of radio waves all over the planet. During World War II the invention of radar triggered a similar death toll.”
https://johnkaminski.org/index.php/john-kaminski-american-writer-and-critic-2/247-pandemic-panic-a-poisoned-psyop
424) Another article I found states the following about the summer of 1918: “The Navy Radio School at Harvard University in Cambridge reports the first cases of influenza among the group of 5,000 young men studying radio communications.”
https://www.acep.org/how-we-serve/sections/disaster-medicine/news/april-2018/1918-influenza-pandemic-a-united-states-timeline/
https://www.acep.org/how-we-serve/sections/disaster-medicine/news/april-2018/1918-influenza-pandemic-a-united-states-timeline/
425) Perhaps it’s no coincidence, then, that the widespread rollout of 5G has coincided with the COVID-19 pandemic.
426) The key takeaway here is that there was no “infectious” virus in the 1918 pandemic—and there isn’t one today, either. So-called “infectious” viruses simply don’t exist.
427) “COVID-19” is merely a catch-all term for various respiratory illnesses that are due to a variety of other causes, such as toxins in the environment, toxic pharmaceuticals, radio waves, etc.—similar to the term “influenza.”
428) This changes the entire way we think about the human body, which is apparently far more powerful than most people might imagine.
429) For one thing, it’s very empowering to know that invisible, predatory microorganisms aren’t just floating around everywhere in the environment, wreaking havoc and causing widespread death and disease—which is what the corrupt medical establishment would have you believe.
430) After all, without an enemy in the form of “germs,” there is no need to create weapons to fight that enemy.
The real enemy is the one creating all these useless (not to mention destructive) weapons, which are actually causing more disease themselves.
The real enemy is the one creating all these useless (not to mention destructive) weapons, which are actually causing more disease themselves.
431) The mainstream medical cartel is working round the clock to manufacture “weapons” to fight their own manufactured “enemy”—invisible “disease-causing” pathogens like their COVID-19 “virus.”
432) This is a gargantuan scam of absolutely epic proportions. Microorganisms like bacteria and viruses are actually beneficial to our health—they are signs of healing. These “pathogens” are simply scavengers at the site of disease, generated by the human body itself.
433) Allopathic medicine is literally targeting and suppressing the very thing that is actually a significant component of the healing process.
Truly sickening, depraved, and unconscionable.
Truly sickening, depraved, and unconscionable.
434) By targeting what is actually a symptom of healing and falsely labeling it as an external invader that causes disease, the healthcare industry is not only committing egregious fraud but also a grossly severe and ongoing crime against humanity that rivals anything in history.
435) So not only are mainstream medical practitioners completely ignoring the actual causes of disease, they are knowingly targeting a beneficial component of healing—which only creates further conditions of disease.
436) The healthcare industry is literally in the business of manufacturing diseases and exacerbating disease conditions.
In essence, they are getting away with murder on a grand scale.
In essence, they are getting away with murder on a grand scale.
437) So, what does all this mean with respect to bacteria and viruses? Béchamp determined that microorganisms such as bacteria and viruses were pleomorphic. In other words, they can change from one form to another; they are not separate, discrete species.
438) But was Béchamp all the way there in terms of having his finger on the “magic of life”?
As far as the general idea, yes, he was—even if he may have gotten some of the specific details wrong.
As far as the general idea, yes, he was—even if he may have gotten some of the specific details wrong.
439) In fact, a remarkable set of experiments was conducted in 1910 by Dr. E. C. Rosenow at the Mayo Biological Laboratories, which he later published in the Journal of Infectious Diseases. These experiments are described in the blog post below.
https://www.helladelicious.com/blog/stories-and-news/2011/01/germ-theory-vs-cellular-theory/
https://www.helladelicious.com/blog/stories-and-news/2011/01/germ-theory-vs-cellular-theory/
440) “Rosenow demonstrated:
‘that simple bacterial forms like streptococci (pus germs) could be made to assume all of the characteristics of pneumococci (pneumonia germs) simply by feeding them on pneumonia virus and making other minor modifications in their environment…’”
‘that simple bacterial forms like streptococci (pus germs) could be made to assume all of the characteristics of pneumococci (pneumonia germs) simply by feeding them on pneumonia virus and making other minor modifications in their environment…’”
441) “‘…And when Rosenow reversed the procedure and fed pneumonia germs on pus, they quickly changed into streptococci. Many other experiments were carried on…in every instance, the germs, regardless of type, changed into other types when…food and environment were altered.’”
442) Simply astonishing. This indicates that microorganisms such as bacteria are indeed pleomorphic, and further implies that there is an elementary unit of life (i.e., Béchamp’s microzyma) from which pleomorphic microorganisms emanate.
443) It’s absolutely disgraceful that the medical establishment hasn’t supported further research that expands upon the experiments conducted by Dr. Rosenow.
You can access the original 1914 article at the link below.
https://www.jstor.org/stable/30073453?seq=1#metadata_info_tab_contents
You can access the original 1914 article at the link below.
https://www.jstor.org/stable/30073453?seq=1#metadata_info_tab_contents
444) Many sources claim that viruses are in fact exosomes, which one author describes as “extracellular vesicles that are released from cells upon fusion of an intermediate endocytic compartment, the multivesicular body (MVB), with the plasma membrane.”
https://bmcbiol.biomedcentral.com/articles/10.1186/s12915-016-0268-z
https://bmcbiol.biomedcentral.com/articles/10.1186/s12915-016-0268-z
445) One such source is Dr. Andrew Kaufman, who has grown in prominence since the start of the COVID-19 pandemic. Here is a brief video of him discussing exosomes and the lack of evidence for a new COVID-19 “virus.”
446) The full video is available at the link below.
447) The following article, however, states that viruses are not exosomes but are actually “bodily cell protein fragments.” Nevertheless, the author still rejects germ theory and supports Béchamp’s ideas of pleomorphism and terrain theory. https://yummy.doctor/blog/kochs-postulates-the-germ-theory-never-satisfies/
448) “…what we call viruses are actually bodily cell protein fragments, generally somatids or microzyma, which sprout from the red blood cell membranes, as has been well understood and studied in the pleomorphic scientific understanding and put forth via the terrain theory.”
449) “Bacteria can become viruses, or morph into fungal forms depending on the triggers from the terrain or milleu of the body. They are meant to be of aid to the health situation of the body.”
450) “Somatids that are created to carry DNA or RNA (covered with a capsule) are designed to repair cellular genetic material and not meant to be pathogenic.”
451) “There are other cells of the body being mistaken for viruses, as many vesicles look similar in nature. For example, exosomes which help to move materials around the body, actually look identical to certain pollens and are often mistaken for ‘viruses.’”
452) Regardless, such specific details are mostly irrelevant in terms of the bigger picture.
The bottom line is that the mainstream medical cartel has duped the entire world with respect to how diseases work—to a staggering degree, I might add.
The bottom line is that the mainstream medical cartel has duped the entire world with respect to how diseases work—to a staggering degree, I might add.
453) It’s outrageous that an entire industry has been created around the faulty notion of “contagious” diseases, while modern medicine almost completely ignores the effect of toxins or irritants in our environment—i.e., the actual causes of disease.
454) This is even more egregious in light of the fact that we already have trillions of bacteria, viruses, and other “pathogenic” microorganisms inside our bodies. How on earth did such a dreadful mix-up ever happen?
455) Simply put: pervasive corruption and propaganda.
Make no mistake—this has been the result of systematic infiltration of the medical establishment by cabalists obsessed with advancing their genocidal, maniacal, and Messianic New World Order agenda.
Make no mistake—this has been the result of systematic infiltration of the medical establishment by cabalists obsessed with advancing their genocidal, maniacal, and Messianic New World Order agenda.
456) This is why Pasteur’s Talmudic connections and Koch’s mentorship by Jews—including a descendent of rabbis—cannot be taken lightly.
457) But is there anything further we can do to fight back against this agenda? Is there a way to prevent a vaccine debacle—like the one during the 1918-20 pandemic—from happening once again?
458) More specifically, has anyone expanded upon or gone beyond Béchamp’s discoveries? Is there any new information we can arm ourselves with in the fight against this worldwide medical tyranny?
Absolutely, yes—information that could blow your mind.
Absolutely, yes—information that could blow your mind.
459) “As has been stated before, all medical and non-medical authorities on vaccination agree that vaccines are designed to cause a mild case of the diseases they are supposed to prevent. But they also know and admit that there is no way whatsoever to predict…”
460) “…whether the case will be mild or severe - even deadly. With this much uncertainty in dealing with the very lives of people, it is very unscientific and extremely dangerous to use such a questionable procedure as vaccination.” – Eleanor McBean, “Swine Flu Expose”
461) “The specific disease doctrine is the grand refuge of weak, uncultured, unstable minds, such as now rule in the medical profession. There are no specific diseases; there are specific disease conditions.” – Florence Nightingale
462) “…the erroneous belief that germs cause disease and must be controlled or eliminated before it can be cured is so widespread as to close the minds of many people to any other ideas on this subject.” – R. B. Pearson, “Pasteur: Plagiarist, Imposter!”
463) “If I could live my life over again, I would devote it to proving that germs seek their natural habitat, diseased tissue – rather than being the cause of the diseased tissue.” – Rudolf Virchow
464) “Doctors are men who prescribe medicines of which they know little, to cure diseases of which they know less, in human beings of whom they know nothing.” – Voltaire
465) “Contrary to the ideas promulgated by the medical establishment, the human body is neither a machine nor a bag of chemicals that is attacked by a ‘disease’. Instead it is an amazing self-regulating organism that has an immense ability to self-heal…”
466) “…The symptoms that are associated with ‘disease’ represent the body’s efforts to expel toxins, repair damage and restore health. As we explain in detail in our book, it is only the body that heals itself.” – Dawn Lester
https://whatreallymakesyouill.com/why-modern-medicine-cannot-cure-the-common-cold/
https://whatreallymakesyouill.com/why-modern-medicine-cannot-cure-the-common-cold/
467) In my research, I stumbled across a resource that is one of the most extraordinary websites I have ever visited—if not the most. It literally turns the entirety of modern medicine on its head.
468) This information renders allopathic medicine thoroughly obsolete—while revealing its truly barbaric, murderous, and genocidal nature.
469) The stunning website details what is known as German New Medicine, created by Dr. Ryke Geerd Hamer.
It has the potential to save countless lives immediately, simply by sharing it with everyone you know—and then letting them make up their own minds.
https://learninggnm.com/home.html
It has the potential to save countless lives immediately, simply by sharing it with everyone you know—and then letting them make up their own minds.
https://learninggnm.com/home.html
470) The essence of GNM is that every so-called “disease” is in fact just a part of the body’s natural healing process, known as a Significant Biological Special Program (SBS)—i.e., “nothing in nature is ‘diseased’ but always biologically meaningful.”
https://learninggnm.com/SBS/documents/gnm_paradigm_opening_page.html
https://learninggnm.com/SBS/documents/gnm_paradigm_opening_page.html
471) GNM centers around five biological laws, which I will briefly summarize here.
https://learninggnm.com/SBS/documents/five_laws.html
https://learninggnm.com/SBS/documents/five_laws.html
472) First Law (“The Iron Rule of Cancer”)
Every “disease,” or SBS, is induced by “an unexpected, highly acute, and isolating conflict shock,” also known as a Dirk Hamer Syndrome (DHS), which occurs simultaneously on three levels—consciousness, brain, and corresponding organ.
Every “disease,” or SBS, is induced by “an unexpected, highly acute, and isolating conflict shock,” also known as a Dirk Hamer Syndrome (DHS), which occurs simultaneously on three levels—consciousness, brain, and corresponding organ.
473) First Law (“The Iron Rule of Cancer”) con’t
Each SBS is handled by the specific part of the brain that controls the function of the affected organ or body part. This can also be referred to as the “psyche-brain-organ” relation.
Each SBS is handled by the specific part of the brain that controls the function of the affected organ or body part. This can also be referred to as the “psyche-brain-organ” relation.
474) Second Law
Every “disease,” or SBS, runs in two phases, as long as there is a resolution of the conflict.
Every “disease,” or SBS, runs in two phases, as long as there is a resolution of the conflict.
475) Second Law con’t
The two phases consist of a conflict-active phase followed by a healing phase. A “hanging conflict” occurs when a person stays in the conflict-active phase due to a conflict that has not yet been resolved.
The two phases consist of a conflict-active phase followed by a healing phase. A “hanging conflict” occurs when a person stays in the conflict-active phase due to a conflict that has not yet been resolved.
476) Third Law
Embryology plays a central role in every “disease,” or SBS. The “psyche-brain-organ” relation is closely connected to the three embryonic germ layers from which all organs originate—the endoderm, mesoderm, and ectoderm.
Embryology plays a central role in every “disease,” or SBS. The “psyche-brain-organ” relation is closely connected to the three embryonic germ layers from which all organs originate—the endoderm, mesoderm, and ectoderm.
477) Fourth Law
There is no such thing as “infectious diseases.” Microbes such as bacteria and viruses do not cause “diseases”—instead, they play a crucial role during the healing phase.
There is no such thing as “infectious diseases.” Microbes such as bacteria and viruses do not cause “diseases”—instead, they play a crucial role during the healing phase.
478) Fifth Law – The Quintessence
Every “disease,” or SBS, has a special biological meaning; the mind-body system is governed by an infinite intelligence, i.e., Mother Nature.
Every “disease,” or SBS, has a special biological meaning; the mind-body system is governed by an infinite intelligence, i.e., Mother Nature.
479) Additionally, these laws “have been tested and verified by several physicians and professional associations through signed documents.” The verifications, available at the link below, “attest to the 100% accuracy of Dr. Hamer’s medical findings.”
https://learninggnm.com/SBS/documents/verifications.html
https://learninggnm.com/SBS/documents/verifications.html
480) If this information resonates with you, I encourage you to share it with others as much as possible. GNM is highly empowering and has the ability to change a person’s life immediately—particularly someone suffering from chronic illness or diagnosed as “terminally” ill.
481) In conclusion, it turns out that all so-called “disease” conditions—no matter what the shockingly inept, archaic, and barbaric mainstream medical community might label them as—are nothing more than finely tuned “special biological programs” dictated by Mother Nature.
482) In particular, Béchamp’s discoveries, combined with the groundbreaking revelations from GNM, render an organization like the CDC (along with virtually the entire medical establishment) totally useless—not to mention destructive, violent, and abhorrent.
483) The human body is already more than well-equipped to handle “disease.” It is the disgusting Rockefeller-inspired medical cartel itself that has undermined the body’s ability to naturally self-heal, with its atrocious, sloppy, and across-the board misdiagnoses of “diseases.”
484) Armed with this powerful information, we can all do our part in chipping away at the grossly inhumane medical tyranny enveloping the world today. We can still avoid repeating a similar genocidal outcome to the one that occurred during the 1918-20 pandemic.
485) If not already, do yourself a favor and let go of fear—ditch the mask, stop social distancing, don’t quarantine at home, and share this valuable information as widely as possible. You have nothing to fear from any “infectious virus.” Fear is the real pandemic.
@threadreaderapp unroll

 Read on Twitter
Read on Twitter